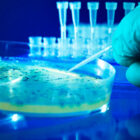

Since 2002, The Myositis Association’s annual research funding program has awarded nearly $8.2 million in research support. We are pleased to announce our 2024 grant awards, funding disease-specific projects in…
Continue Reading
Since 2002, The Myositis Association’s annual research funding program has awarded nearly $8.2 million in research support. We are pleased to announce our 2024 grant awards, funding disease-specific projects in…
Continue Reading
Dermatologist Dr. David Fiorentino is excited about the possibilities of cell therapies to treat autoimmune conditions like dermatomyositis (DM). In collaboration with rheumatologists and bone marrow transplant specialists at Stanford…
Continue Reading
The Family and Medical Leave Act (FMLA) has long been a cornerstone of employee rights in the United States, providing eligible employees with up to 12 weeks of unpaid, job-protected…
Continue Reading
Two important changes have been made to Medicare Part D in 2025 that may help make the cost of your prescription drugs more affordable and more manageable.
Continue Reading
By Lindsay Key People living with myositis learned about research to advance understanding and treatment of the disease during presentations and a tour of the National Institutes of Health (NIH)…
Continue Reading